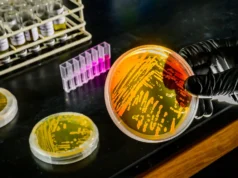
O aquecimento dos oceanos pode melhorar pequenos micróbios que controlam os nutrientes dos oceanos

Um pequeno número de empresas está trabalhando em computadores biológicos
Floriana/Getty Images
Os data centers utilizam enormes quantidades de energia e a procura por chips é altíssima – poderão as células cerebrais ser a resposta? A startup Cortical Labs, com sede na Austrália, anunciou que está construindo dois data centers “biológicos” em Melbourne e Cingapura, equipados com chips contendo os mesmos neurônios que comprovadamente funcionam. Pong ou Catástrofe.
A Cortical Labs é uma das poucas empresas que desenvolve computadores biológicos, que consistem em células nervosas conectadas a conjuntos de microeletrodos que podem estimular e medir as respostas das células ao inserir dados. No início deste mês, a empresa demonstrou que seu principal computador, o CL1, poderia aprender a jogar Catástrofe em uma semana.
Agora, o Cortical Labs revelou os dois data centers que planeja construir. O primeiro, em Melbourne, conterá cerca de 120 unidades CL1. O segundo, construído em colaboração com a Universidade Nacional de Singapura, irá inicialmente abrigar 20 CL1s, mas a empresa espera eventualmente abrigar 1.000 unidades em um data center maior, assim que receber a aprovação regulatória. A Cortical Labs afirma que isso permitirá expandir seus serviços de computação cerebral baseados em nuvem.
Computadores biológicos como o CL1 estão sendo construídos e testados por grupos de pesquisa em todo o mundo, mas muitas vezes são difíceis de construir e difíceis de usar pelas pessoas, afirmou. Miguel Barros na Universidade de Essex, Inglaterra. “Gastamos muito dinheiro e suor construindo este (sistema).”
“O que (Cortical Labs) está fazendo é essencialmente tornar seus biocomputadores acessíveis em grande escala”, disse Barros, que usou os serviços em nuvem da Cortical Labs como parte de sua pesquisa. “Eles serão os primeiros a fazer isso.”
Embora este sistema possa ser treinado para tarefas relativamente simples, como jogar CatástrofeA forma exata como esses neurônios funcionam e a melhor forma de treiná-los para realizar tarefas como aprendizado de máquina ainda não está clara, disse Segure Scherertambém na Universidade de Essex. “Ter acesso a isso permite explorar o aprendizado, o treinamento e a programação”, disse ele. “Você não programa neurônios como um computador padrão.”
A Cortical Labs argumenta que seus data centers também exigem muito menos energia do que os sistemas de computação típicos e afirma que cada CL1 requer cerca de 30 watts, em comparação com os milhares de watts exigidos pelos chips convencionais de IA avançada.
“Quando ampliarmos e transformarmos uma sala inteira, como acontece agora com os servidores de dados, haverá uma enorme economia de energia”, disse Paulo Barata na Universidade de Loughborough, Inglaterra. Existem outros recursos que um data center biológico pode precisar, como nutrientes para alimentar e manter os chips neurais vivos, mas estes exigem muito menos resfriamento do que a computação convencional, disse ele. “A quantidade de energia economizada pelos números (do Cortical Labs) é bastante conservadora.”
No entanto, a tecnologia ainda está em seus estágios iniciais, disse ele. Que velho Scheper na Oxford Brookes University, Reino Unido, que trabalhou com a empresa rival de computação biológica FinalSpark. “Será que isso terá tanto sucesso quanto as pessoas pensam? Não, ainda estamos nos estágios iniciais de desenvolvimento.”
É difícil fazer uma comparação direta de tamanho, porque o chip CL1 não pode realizar cálculos convencionais como os típicos chips de IA baseados em silício, mas o data center biológico proposto teria centenas de chips biológicos, em comparação com as centenas de milhares de unidades de processamento gráfico (GPUs) vistas nos maiores data centers de IA.
“Acho que ainda falta muito para estar pronto para produção. Este é um grande passo de pequenas redes que jogam jogos de computador para grandes modelos de linguagem”, disse Steve Furber na Universidade de Manchester, Inglaterra.
Um problema que permanece é que ainda não está claro como armazenar os resultados do treinamento desses neurônios na memória, ou como executar algoritmos computacionais reais neles, em vez de treiná-los para usos específicos, como jogar videogame.
Outro desafio é como treinar novamente os neurônios depois de terem concluído uma tarefa específica. “Tudo o que foram treinados para fazer é perdido quando a cultura termina, por isso é necessário haver uma reciclagem adequada”, disse Scherer. “Então não é uma solução ideal manter a tecnologia se você precisar treinar novamente a cada 30 dias.”
Tópico: